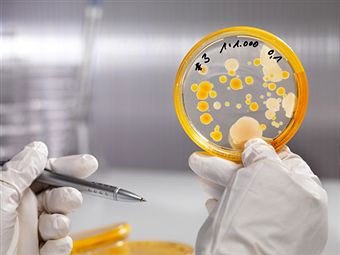
image

Причины дисбактериоза влагалища
Причины дисбактериоза влагалища очень многоплановые. Среди основных провоцирующих факторов можно выделить стрессы, общие заболевания, переохлаждения, антибиотикотерапию, несоблюдение правил гигиены особенно в период менструации. Среди других причин вагинального дисбактериоза также отмечают:
Кроме того, использование неправильно подобранных контрацептивов, кортикостероидные и цитостатические препараты также могут влиять на гормональный баланс и, как следствие, на микрофлору влагалища.
Диагностика вагинального дисбактериоза
Стандартная диагностика дисбактериоза включает в себя:
- гинекологический осмотр;
- мазок на микрофлору;
- анализ на полимеразную цепную реакцию;
- влагалищный посев.
Перед сдачей мазка важно несколько дней воздержаться от половых контактов, использования вагинальных свечей и спринцевания.
Мазок сдается до начала лечения и по его окончанию.
ПРЦ-анализ необходимо сдавать для определения возбудителя инфекции и количества бактерий в организме. В свою очередь, взятие посева помогает определить свойства, присущие возбудителю. Также нужно определить чувствительность организма к антимикробным средствам.
Признаки и симптомы дисбактериоза влагалища
Начало дисбактериоза практически никак не проявляется и может протекать малозаметно. Незначительное изменение характера влагалищных выделений, как правило, остается незамеченным. Однако дальнейшее развитие заболевания приводит к появлению ряда более характерных симптомов:
- зуд и жжение в области влагалища;
- болезненность и ощущение сухости во влагалище во время полового акта;
- рези и боли в области половых органов и внизу живота;
- появление обильных выделений из влагалища, имеющих желтоватый оттенок и неприятный запах, который напоминает «гнилую рыбу».
Если же дисбактериоз влагалища прогрессирует, то возникает риск развития воспалительных заболеваний половой сферы,что влечет к появлению следующих признаков:
- бели сменяются гнойными (кольпит);
- при мочеиспускании появляются рези (цистит);
- иногда встречаются случаи повышения температуры (восходящая инфекция в половой и мочевыделительной системах)
Опасность представляет игнорирование коррекции баквагиноза. В результате у женщины может развиться хронический (постоянный) дисбактериоз влагалища, характеризующийся периодами обострений и ремиссий.
Лечение нарушенной влагалищной микрофлоры
Столкнувшись с этой проблемой, женщины обычно задаются вопросом «как восстановить микрофлору влагалища после приема антибиотиков». Лечение дисбактериоза состоит из 3-х этапов, включающих в себя антибактериальную терапию, заселение флоры полезными микроорганизмами и восстановление иммунитета.
Антибактериальная терапия необходима для «усмирения» бурно развивающихся колоний вредоносных бактерий. Среди лекарств, назначаемых на этом этапе, выделяют Фурозалидон, Амоклав, Трихопол, Сумамед, Далацин и т.п. Помимо таблеток используются суппозитории (свечи), крема, а также различные ванночки и тампоны, пропитанные противовоспалительными растворами. Они могут быть как химического, так и растительного характера. Например, ванночки из ромашковой воды. Среди свечей, применяемых в антибактериальной терапии, наиболее эффективными являются Гексикон и Флагил на основе хлоргексидина и метронидазола.
Параллельно с уничтожением возбудителей заболеваний, осуществляется восстановление микрофлоры в гинекологии с использованием дополнительных препаратов. Оно может производиться как перорально (внутрь в форме таблеток), так и внутривагинально с использованием свечей, содержащих в себе штаммы ацидофильных бифидобактерий. Последний способ более предпочтителен, а первый универсален не только для влагалища, но и для организма в целом. Ведь лактобактерии также живут и в кишечнике любого человека.
У свечей, в отличие от таблеток нет противопоказаний. Их можно использовать даже беременным женщинам. Самые известные представители: Бифидумбактерин, Ацепол, Ацилакт, Нормофлорин и Кипферон, а также Лактобактерин в виде таблеток и порошка для приготовления растворов. Нормализация микрофлоры после антибиотиков у женщин длится на протяжении 10-ти дней. Если в этот период происходят менструационные кровотечения, то лечение суппозиториями откладывается до тех пор, пока они не закончатся.
Третий этап подразумевает поднятие иммунитета и общее укрепление с использованием иммуномодулирующих средств. В их числе Циклоферон (таблетки) и Иммунал (капли или таблетки).
Осложнения дисбактериоза влагалища
Во-первых, к числу наиболее частых осложнений относятся воспалительные процессы, которые возникают на стенках влагалища (вагинит), на шейке матки (цервицит), ее полости (эндометрит (Endometritis) и придатках (аднексит), брюшины (перитонит (Peritonitis). Начало воспаления можно определить по существенному увеличению объема выделений и появлению зуда и жжения.
Во-вторых, при дальнейшем распространении инфекции по влагалищу, она может вызвать не только воспаление в полости матки, ее придатках или в яичниках, но и способствовать попаданию болезнетворных микроорганизмов в мочеиспускательный канал, что в большинстве случаев заканчивается уретритом (Urethritis), циститом, пиелонефритом (Pyelonephritis).
LiveInternetLiveInternet
Нарушение микрофлоры влагалища хотя бы раз в жизни беспокоило любую женщину. С этой болезнью сталкиваются и девушки, которые никогда не жили половой жизнью. Протекает недуг бессимптомно, но может вызывать самые тяжелые последствия, сопровождающиеся воспалительным процессом. Гинекологи называют патологию дисбиозом или дисбактериозом.
Дисбиоз определяется как нарушение микрофлоры влагалищной среды. Если его не лечить, то болезнь будет прогрессировать, вызвав при этом ряд самых негативных последствий.
Нарушение микрофлоры влагалища на первом этапе никак себя не проявляет. Меняются лишь в незначительной степени выделения. В нормальном состоянии у женщины они отсутствуют, а если и бывают, то в малом количестве. При здоровой микрофлоре не бывает резей, болей, запаха, чувства жжения, сухости во время полового акта и дискомфорта.
Неприятный запах, увеличение количества беловато-желтоватых выделений говорят о наличии такой патологии, как нарушение микрофлоры влагалища. Почему это происходит? Об этом и пойдет речь дальше.
Нормальная микрофлора на 90 % состоит из лактобактерий и на 9 % — из бифидобактерий. Оставшийся 1 % приходится на условно-патогенные микроорганизмы, которые редко провоцируют какие-либо заболевания. Незначительные изменения организм женщины легко переносит, особенно при хорошем иммунитете. При серьезных нарушениях, где число лактобактерий и бифидобактерий уменьшается, а процент условно-патогенных микроорганизмов растет, половая система может дать сбой. В результате происходит размножение таких вредоносных бактерий, как грибок, гарднерелла, стрептококк, протей, кишечная палочка, хламидии и т. д. Возникает дисбактериоз влагалища и, как следствие, воспалительный процесс. Иммунная система продолжает бороться с патогенными бактериями, но при отсутствии лечения защитные функции организма уже не дают нужного эффекта.
Если дисбактериоз протекает в скрытой форме, то выраженная симптоматика наблюдается редко. Без анализов и осмотра врача распознать заболевание в подобном виде бывает сложно. Поэтому женщинам рекомендуют посещать гинеколога два раза в год.
- Однократное и постоянное переохлаждение, которое снижает иммунитет и способствует развитию дисбактериоза.
- Изменение гормонального фона. Бессистемная половая жизнь, климакс, беременность, рождение ребенка, аборт, нарушение менструального цикла и т. д.
- Смена климатических поясов.
- Стрессовые ситуации.
- Хаотичная сексуальная жизнь. Частая смена половых партнеров. Игнорирование методов контрацепции.
- Воспалительные и инфекционные заболевания малого таза.
- Инфекции, приобретенные после полового акта.
- Продолжительное лечение антибиотиками.
- Кишечные заболевания.
- Неправильное введение и использование тампонов для месячных.
Помогут вовремя распознать нарушение микрофлоры влагалища симптомы заболевания. Хотя во многих случаях, особенно на начальной стадии заболевания, они попросту отсутствуют. Если бактериоз начал прогрессировать, могут наблюдаться:
- выделения белого и желтого цвета;
- неприятный запах;
- дискомфорт в районе половых органов;
- сухость во время секса;
- жжение, зуд и боль в области гениталий.
Это основные признаки нарушения микрофлоры влагалища. Если дисбиоз не лечить, то может возникнуть эндометрит, воспаление придатков, шейки матки или стенок влагалища. Если инфекционный процесс затронул мочеполовые органы и мочеиспускательный канал, то, как правило, развивается цистит или уретрит.
Беременность, изменение гормонального фона могут спровоцировать острую стадию вагинального дисбиоза. В период вынашивания ребенка симптоматика заболевания усугубляется. Наблюдается обилие выделений, беспокоит неприятный запах, зуд и жжение в области гениталий, возникают болевые ощущения во время секса.
Женщинам в период беременности многие препараты противопоказаны, поэтому полноценное лечение здесь провести не представляется возможным. Все действия направляются лишь на временное устранение симптомов, а необходимое лечение с приемом антибиотиков проводится после родоразрешения.
Может возникать нарушение микрофлоры влагалища после родов. Как лечить пациентку в этой ситуации? Этот вопрос решает только врач. Зачастую у молодых мам диагностируется молочница, которую вызывает дрожжеподобный гриб рода Candida. На этот процесс оказывает влияние гормональная перестройка организма, а также ряд лекарственных препаратов, которые была вынуждена принимать рожавшая женщина.
В этом случае терапию проводят противогрибковыми средствами в комплексе с пробиотиками, которые положительным образом влияют на миклофлору влагалища и предупреждают вторичное появление болезни.
Зачастую нарушение баланса микрофлоры влагалища не влияет на половую жизнь женщины и не вызывает у сексуального партнера особых проблем. Исключением является запущенная стадия дисбиоза. В этом случае у мужчины могут развиться признаки баланопостита или неспецифического уретрита, и то только в том случае, если представитель сильного пола имеет предрасположенность к заболеванию.
Как правило, болезни полового партнера не влияют на влагалищную среду женщины, разумеется, речь не идет о венерических заболеваниях.
Лечение дисбиоза влагалища проводится только у женщин, без привлечения партнера, если только патология не вызвана половой инфекцией.
Если имеют место ЗППП, то они сопровождаются выраженным дисбактериозом. Вызывают дисбаланс во влагалищной среде. Провоцируют появление воспалительного процесса и нарушают микрофлору вагины. Однако нет таких ситуаций, где возбудителем выступает только инфекция, передающаяся половым путем. Всегда болезнь сопровождается негативными изменениями в условно-патогенной микрофлоре. Это следует учитывать в борьбе с недугом. Здесь прием одних антибиотиков вряд ли поможет, так как не восстановит нормальный уровень микрофлоры.
Всегда курс лечения должен заканчиваться прибиотиками, восстанавливающими влагалищную среду. Серьезные проблемы, вызванные хламидиями и трихомонадой, решают путем антибактериальной терапии, после которой необходимо восстановление микрофлоры. Эти курсы должны быть разделены и проводятся один за другим.
В ситуациях, когда заболевание имеет легкую форму, нужно провести урогенитальную диагностику. А восстановливать необходимый фон можно одновременно с устранением половой инфекции.
Нарушение микрофлоры влагалища встречается даже у девушек, которые ни разу не вступали в половую связь. Здесь оказывают влияние самые различные факторы. Это и гормональная перестройка организма во время полового созревания, и особенности структуры девственной плевы, и несоблюдение правил гигиены (в том числе неправильное подмывание гениталий), и прием антибиотиков и других препаратов. Причины в этом случае схожи с факторами, способствующими развитию дисбактериоза у женщин, ведущих активную половую жизнь. Но есть и нюансы.
В отличие от женщин, у девушек редко наблюдаются обильные выделения, так как девственная плева не дает им выходить из влагалища в полном объеме. Определенная их часть скапливается в малом тазу, что вызывает воспалительный процесс. Также в начале освоения половой жизни у девушек много бактерий попадает из влагалища в мочеиспускательный канал, что может вызвать «цистит медового месяца».
Терапия дисбактериоза у девственниц достаточно сложна, так как девственная плева не позволяет провести тщательную обработку влагалища. В некоторых случаях показана даже гименэктомия, при которой происходит нарушение плевы.
Зачастую некоторые заболевания желудка и кишечника приводят к нарушению микрофлоры как в стенках кишечника, так и во влагалище.
Прямая кишка тесно соприкасается с влагалищной полостью, в результате бактерии беспрепятственно проходят сквозь стенки органов. Когда дисбактериоз кишечника развивается и прогрессирует, бактерии (кишечная палочка, энтерококки и т. д.), вызывающие эту болезнь, легко проникают сквозь стенки влагалища, где тоже нарушают фон. Что делать в такой ситуации? Разумеется, обращаться к специалисту, ни в коем случае не прибегая к «самодеятельности» и помощи народных средств.
Лечение нарушения микрофлоры влагалища в данном случае — процесс сложный, так как вероятность нового заражения довольно высока. Здесь должна проводиться одновременная терапия и влагалища, и кишечника. Это самая тяжелая форма дисбиоза.
Для того чтобы лечение дало результат, нужно правильно диагностировать недуг. В первую очередь проводится гинекологический осмотр пациентки. Затем назначаются анализы. Как правило, это:
- ПЦР-диагностика, позволяющая убедиться в отсутствии или наличии половых инфекций;
- мазок на флору, говорящий о состояние влагалищной микрофлоры;
- посев выделений из влагалища;
- определяется чувствительность больной к антибиотикам.
Полученные данные лабораторных исследований позволяют установить причину болезни и степень её сложности.
- Уничтожение патогенных бактерий, которые стали причиной этого заболевания.
- Восстановление влагалищной микрофлоры.
- Повышение иммунитета.
Если дисбактериоз возник из-за половых инфекций, то сначала устраняют возбудителя заболевания, назначив курс антибиотиков. Если нарушение микрофлоры влагалища вызвано другой причиной, то антибиотики могут и не применяться. А если и прописывают подобную терапию, то на срок не более пяти дней.
Очень важно при дисбиозе проведение наружных процедур. Это различные ванночки и тампоны. Подобные мероприятия тормозят развитие патогенных микроорганизмов и восстанавливают иммунитет. Лечение нарушения микрофлоры влагалища антисептиками — их в этом случае применяют местно — намного эффективнее антибиотиков, да и зона воздействия у них гораздо шире. Почти все бактерии восприимчивы к их влиянию. Ещё антисептические средства помогают развить иммунитет стенок вагины и нормализуют её микрофлору. Тормозят размножение патогенных бактерий.
Запущенную форму дисбактериоза тяжело вылечить только иммуномодулирующей терапией, здесь в дополнение почти всегда прописывают антибиотики.
Нарушение микрофлоры влагалища (препараты, как правило, назначают в виде мази, свечей, вагинальных таблеток и кремов) — достаточно сложное заболевание, при котором зачастую требуется комплексный подход.
Часто для лечения дисбактериоза применяют крем «Далацин», который является антибиотиком с широким спектром действия. Действующее вещество — клиндамицина фосфат 2 %. Он
интенсивно воздействует на вагинальную микрофлору. Также эффективно восстанавливают фон при такой патологии, как нарушение микрофлоры влагалища, свечи «Далацин». Они содержат до 100 мг антибиотика.
Хороший результат при вагинальном дисбиозе дают свечи «Флагил». Препарат используют один раз в день, на ночь. Также для лечения заболевания врачи рекомендуют использовать «Гексикон» — это свечи с хлоргексидином. Их вводят в полость влагалища один раз в день. Курс -10 дней.
Для лечения дисбиоза вагины многие сегодня выбирают свечи «Бетадин» и «Тержинан». Хороший эффект дает и гель «Метронидазол».
Если болезнь запушена, и только препаратами местного действия нельзя обойтись, то прописывают для приема внутрь таблетки. Это:
- «Орнидазол».
- «Наксоджин».
- «Мератин».
- «Тиберал».
- «Тинидазол».
- «Трихопол» или «Метронидазол».
- «Клиндамицин».
Лекарственные препараты принимают на протяжении недели. Следует помнить, что при применении пероральных средств употребление алкоголя запрещено. Особенно это касается «Трихопола».
В комплексе с остальными лекарствами для нормализации микрофлоры назначается: «Линекс», «Пробифор», «Бифидумбактерин», «Бифиформ», «Бифидин» или «Бифилиз». Для увеличения количества лактобактерий во влагалищной среде прописывают «Ацилакт», «Лактобактерин», «Ацепол» и т. д. Лекарство рекомендуют пить курсом, начиная со второго дня приема антибактериальных средств. Также назначают средства для поддержания иммунитета — «Иммунал», «Циклоферон» и др.
Если причиной нарушения микрофлоры стала половая связь, то следует обследовать и лечить сексуального партнера тоже.
Лечение дисбиоза может занять до четырех недель. Предупредить это заболевание в ряде случаев бывает сложно, так как настоящую причину, вызвавшую болезнь, установить трудно. Единственное, что может сделать женщина, это укреплять иммунитет и соблюдать необходимые правила гигиены.
После восстановления микрофлоры влагалища следует посещать гинеколога каждые три месяца в течение года. Это нужно для того, чтобы вовремя выявить рецидив и принять соответствующие меры. В дальнейшем, при нормальном стечении обстоятельств, к врачу можно обращаться раз в год.
14 способов, как коты демонстрируют вам свою любовь Нет никаких сомнений в том, что кошки любят нас настолько, насколько мы их любим. Если вы не относитесь к разряду людей, относящихся благосклонно к эт.
Зачем нужен крошечный карман на джинсах? Все знают, что есть крошечный карман на джинсах, но мало кто задумывался, зачем он может быть нужен. Интересно, что первоначально он был местом для хр.
До ужаса красивы:15 шокирующих пластических операций, завершившихся плачевно Пластическая хирургия среди звезд остается невероятно популярной и по сей день. Но проблема в том, что раньше результат не всегда оказывался идеальным.
Эти 10 мелочей мужчина всегда замечает в женщине Думаете, ваш мужчина ничего не смыслит в женской психологии? Это не так. От взгляда любящего вас партнера не укроется ни единая мелочь. И вот 10 вещей.
11 странных признаков, указывающих, что вы хороши в постели Вам тоже хочется верить в то, что вы доставляете своему романтическому партнеру удовольствие в постели? По крайней мере, вы не хотите краснеть и извин.
7 частей тела, которые не следует трогать руками Думайте о своем теле, как о храме: вы можете его использовать, но есть некоторые священные места, которые нельзя трогать руками. Исследования показыва.
Дисбактериоз влагалища: лечение
Для того, чтобы не получить осложнения при нарушении микрофлоры половых органов, женщина должна при первых подозрительных симптомах обратиться к врачу и сдать анализ на дисбактериоз влагалища. Даже обычный профилактический ручной осмотр позволит выявить нарушение состояния микрофлоры влагалища, а дополнительные методы исследования (микробиологическое исследование мазка, бакпосев и ПЦР-анализ) позволят быстро поставить точный диагноз и назначить лечение.
Лечение дисбактериоза влагалища направлено, в первую очередь, на устранение болезнетворных бактерий, которые активно размножаются на слизистой поверхности влагалища. Для этого в большинстве случаев применяют местные антисептические препараты или антибиотики. Форма выпуска таких препаратов – вагинальные таблетки или свечи. При этом на первый план выходит необходимость индивидуального подбора лечения, которое зависит от результатов лабораторных исследований. Обычно после диагностики дисбиоза назначают Метрогил и Далацин – местные препараты, вводимые в полость влагалища. Также могут быть прописаны вагинальные свечи Ацилакт или Нео-Пенотран.
Как избавиться от дисбиоза
Терапия включает несколько направлений.
- Избавление от патогенных микроорганизмов и подавление их роста. Для этого применяются лекарственные препараты как системного, так и местного действия. Медикаменты подбирает врач, как и продолжительность терапии. По завершении курса женщина сдает анализы для определения концентрации возбудителя и лактобактерий.
- Восстановление полезной микрофлоры. Для этого могут применяться лекарственные препараты, содержащие лактобактерии, или назначаться коррекция питания. Важно скорректировать меню.
- Коррекция образа жизни. Соблюдение некоторых рекомендаций поможет быстрее восстановить микрофлору влагалища и предупредить рецидив. Сюда относятся отказ от алкоголя и курения, забота о женском здоровье, избегание переохлаждения, отказ от ношения синтетического нижнего белья.
Если доктор назначил антибактериальную терапию, необходимость лечения партнера зависит от выявленного возбудителя. Сам по себе дисбиоз не передается половым путем, поэтому лечение может быть назначено только женщине. Если же источником возбудителя стала половая инфекция, терапия потребуется обоим партнерам.
Внимательно следите за своим здоровьем, наблюдая за периодичностью менструального цикла и характером ежедневных выделений. При любых настораживающих изменениях лучше обратиться к врачу для получения своевременной консультации и предупреждения вялотекущих хронических заболеваний. Запущенные патологии женской репродуктивной системы лечатся сложно и часто имеют необратимые последствия для здоровья. Чем раньше обнаружены откронения в составе флоры, тем проще их устранить.
Как лечить дисбактериоз влагалища народными способами?
- Облегчить симптомы дисбактериоза влагалища у женщин помогает сок алоэ, смешанный в равных пропорциях с оливковым маслом.
- Хорошую помощь в лечении нарушений микрофлоры влагалища оказывает облепиховое масло.
Облепиховое масло при дисбактериозе
- Также полезным будет употребление внутрь отваров некоторых растений. Например, для лечения нарушений микрофлоры влагалища можно приготовить отвар из столовой ложки черемухи, залитой стаканом воды и прокипяченной на медленном огне в течение четверти часа.
Нормализация микрофлоры народными средствами
Некоторые женщины с опаской относятся к традиционной медицине. В этом случае на помощь приходят народные средства. Однако следует учесть, что не всегда такие методы терапии действительно лечат.
Народная медицина помогает только в том случае, если подходить к вопросу лечения с умом. Это означает, что полностью отвергать помощь гинеколога не стоит. Врач назначает основной курс терапии, ставит диагноз. Пациентка вправе прибегать к нетрадиционным методам лечения, однако, перед применением какого-либо способа лучше посоветоваться с лечащим врачом.
Основными методами терапии в народной медицине считаются следующие процедуры:
- спринцевания травами;
- принятие травяных настоек внутрь;
- изготовление лечебных тампонов;
- принятие ванны с добавление трав и солей.
Довольно эффективными являются щелочные ванны. Приготовить раствор для лечения очень просто. Для этого нужно растворить одну столовую ложку соды в литре кипяченой воды и добавить в полученную смесь 50 капель йода. Эффект от такой ванны наблюдается только в том случае, если женщина принимает ее регулярно по 30 минут через день.
Спринцеванием нужно заниматься только с разрешения гинеколога. Дело в том, что данная процедура вымывает не только патогенных бактерий, но и полезную микрофлору. Если же противопоказаний для проведения процедуры нет, то можно приступать к спринцеванию. Для этой цели лучше всего подойдут травы, которые обладают антисептическими свойствами: шалфей, зверобой, ромашка, и т.д.
Дисбактериоз влагалища при беременности
Инфекция во влагалище у беременных – очень частый случай. До 70% беременных в первом триместре сталкиваются с влагалищным дисбактериозом или молочницей. Это объясняется серьезными гормональными перестройками в организме, которые могут спровоцировать сухость влагалища и, как следствие, нарушение нормального бактериологического баланса слизистой. Нелеченый дисбактериоз влагалища несет в себе угрозу преждевременных родов, невынашивания беременности или заражения ребенка во время родов, поэтому обращение к врачу просто необходимо.
Однако производители отмечают необходимость предварительной консультации с врачом для правильного выбора препарата и его дозировки. Кроме местной терапии обычно требуется некоторая корректировка питания будущей мамы.
Дисбактериоз влагалища у беременных
Для чего нужен гликоген
Важным критерием резистентности вагинального эпителия считается уровень гликогена. Он содержится преимущественно в поверхностных клетках. Поскольку клетки регулярно слущиваются и подвергаются цитолизу, гликоген высвобождается и обеспечивает питательный субстрат для нормальной влагалищной микрофлоры. Также гликоген способствует регенерации тканей. Он считается важным углеводным компонентом организма, который принимает участие в образовании иммунных тел. Гормональные изменения, возникающие в течение жизни женщины (пубертатный период, беременность, менопауза) влияют на интенсивность ферментативных процессов во влагалище и на состояние его микрофлоры.
С вступлением женщины в период постменопаузы в генитальном тракте значительно уменьшается уровень эстрогенов и гликогена. Также снижается количество лактобактерий. Качественный состав вагинальной среды становится скудным. В нем больше преобладает облигатно-анаэробные бактерии. В этот период pH влагалищной микрофлоры достигает нейтральных значений.
Профилактика дисбактериоза влагалища
Несмотря на то, что возможности развития дисбактериоза слизистой влагалища подвержено большинство женщин, при соблюдении профилактических мер этого неприятного заболевания можно избежать. К числу обязательных профилактических мер относится следующее:
Согласно клиническому исследованию, проведенному А. В. Игнатовским и Е. В. Соколовским на базе кафедры дерматовенерологии СПбГМУ им. акад. И.П. Павлова, хорошие результаты в комплексной терапии дисбактериоза влагалища дает восстанавливающий гель Гинокомфорт с эфирным маслом чайного дерева. Гель использовался в качестве дополнительного средства после проведения этиотропной терапии.
Что нужно знать после восстановления дисбаланса влагалищной микрофлоры
Кроме приема антибактериальных и иммуномодулирующих препаратов, а также лактобактерий, необходимо поддерживать здоровый образ жизни, чтобы лечение оказалось эффективным без возникновения рецидивов. Крайне не рекомендуется употребление алкоголя, курение, бесконтрольный прием антибиотиков и гормональных средств, не имея на то особых показаний врача. В случае, если можно лечить какое-либо возникшее заболевание без использования антибиотических препаратов, то эту возможность обязательно нужно использовать и прибегать к ним исключительно по необходимости. Кроме того, необходимо рационально питаться, обязательно следить за своей гигиеной и сном, избегать случайных и незащищенных половых связей.
Таким образом, для того, чтобы восстановить флору влагалища после антибиотиков, требуется не так уж и много, если не учитывать медикаментозное лечение. Лишь вкупе с соблюдением всех рекомендаций гинеколога, терапия дает положительный эффект, а дисбактериоз надолго перестанет приносить беспокойство. Не следует относиться к этому с безразличием, ведь от результата будет во многом зависеть будущее женщины.
Нарушения микрофлоры влагалища: видео
Врачи-гинекологи научно-исследовательской клиники Медхелп и дисбактериозе влагалища.. Источник — HealthCare
Биопленки при бактериальном вагинозе. Березовская Е.С., Макаров И.О., Гомберг М.А., Боровкова Е.И., Чулкова Е.А., Аракелян Л.А. // Акушерство, гинекология и репродукция. — 2013. — 2: С. 34-36.
Nonspecific vaginitis. Diagnostic criteria and microbial and epidemiologic associations. Amsel R., Totten P.A., Spiegel C.A. et al. // Am. J. Med. — 1983. — Р. 74:14
Сравнительная эффективность местной терапии бактериального вагиноза у беременных с ожирением. Макаров И.О., Боровкова Е.И. // Акушерство, гинекология и репродукция. — 2012. — 3: С. 14-17.
Почему возникает болезнь
Периодически микрофлора влагалища нарушается, тогда число бифидобактерий либо лактобактерий понижается, а количество условно-патогенных микроорганизмов возрастает. Именно тогда начинается дисбактериоз влагалища.
Причины нарушения баланса микрофлоры
К патологическому сдвигу микрофлоры влагалища в большинстве случаев приводят нарушения в образе жизни. Среди основных причин гинекологи выделяют следующие.
- Негативные особенности образа жизни – стресс, резкие изменения климатических условий, продолжительная усталость, несоблюдение норм гигиены, ношение синтетического белья.
- Нарушение микрофлоры кишечника. Часто встречается состояние, когда во влагалище попадает микрофлора кишечника, вызывая заболевание.
- Воспалительные заболевания в органах малого таза.
- Длительная антибиотикотерапия.
- Гормональные нарушения, которые могут быть вызваны медицинскими проблемами или физиологическими изменениями, – родами, беременностью, климаксом, абортом, гинекологическими заболеваниями, применением гормональных препаратов.
Спровоцировать дисбиоз также могут заболевания, передающиеся половым путем, поэтому при тенденции к смене партнеров лучше предохраняться барьерными методами. В некоторых случаях изменения микрофлоры могут произойти при появлении нового партнера. Через некоторое время регулярных отношений рецидивы исчезают.
Норма и патологии
Особенностью нормальной микрофлоры влагалища у здоровых женщин репродуктивного возраста считается многообразие ее видового состава. Согласно данным исследований, у 87-100% женщин во влагалищной микрофлоре выявляются аэробные микроорганизмы, среди которых наиболее часто встречаются лактобактерии (44-89%), стрептококки (52-70%, энтерококки (25-30%), коагулазо-негативные стафилококки (35-90%), полиморфные микроорганизмы.
Нормальная микрофлора влагалища подразделяется на 3 вида:
- Облигатная. Непатогенные и условно-патогенные микроорганизмы входят в состав микрофлоры, предотвращают развитие патогенных микробов, попавших во влагалище.
- Факультативная. К факультативным микроорганизмам относятся стафилококки эпидермальные, стрептококки группы B и другие виды стрептококков. Также в состав микрофлоры входят грамположительные (лактобациллы) и грамотрицательные палочки (палочка Фридлендера). Факультативные микроорганизмы достаточно часто встречаются у здоровых женщин.
- Транзиторная. На долю транзиторных микроорганизмов приходится 3-5% микрофлоры влагалища. Они представлены более чем 20 видами анаэробов. Среди них особое внимание уделяется Гарднерелле вагиналис, вибрионам рода Mobilincus и дрожжеподобным грибам Candida, которые часто приводят к развитию дисбиотических состояний.
Транзиторные микроорганизмы заносятся в генитальный тракт случайным образом из окружающей среды. При нормальном биотопе они находятся во влагалище недолго и быстро выводятся с током слизи и за счет деятельности мукоцилиарного эпителия. В случае нарушения защитных механизмов условно-патогенные и патогенные микроорганизмы факультативной или транзиторной флоры прикрепляются к клеткам эпителия влагалища, активно размножаются и приводят к повреждению тканей.
Чрезвычайно важными считаются защитные свойства влагалищной жидкости, которые обусловлены иммунологическими механизмами. Кроме иммуноглобулинов, их обеспечивают иммунокомпетентные и макрофагальные клетки. Влагалищная жидкость содержит эпителий, бактерии, лейкоциты, молочную кислоту. Качественный и количественный состав изменяется при аборте, лечении антибиотиками, гормональных нарушениях, влиянии неблагоприятных факторов внешней.
Последствия дисбиоза
Лактобактерии во влагалище женщины поддерживают реакцию среды, при которой патогенные микроорганизмы не могут активно размножаться. Уменьшение количества полезных бактерий ослабляет защитные свойства и дает возможность расти возбудителям заболевания. Результатом дисбиоза может стать появление следующих патологий:
- вагинита;
- молочницы;
- гарднереллеза;
- микоплазмоза;
- трихомониаза;
- уретрита;
- цистита и других.
Кроме того, развитие патогенов провоцирует появление воспалительных реакций, которые приводят к неинфекционным заболеваниям органов малого таза. Результатом нарушения микрофлоры может быть бесплодие, невынашивание беременности, заболевания шейки матки.
Бывает ли дисбактериоз половых органов у мужчин?
Многие представители сильного пола начинают сильно беспокоиться, когда узнают, что занимались незащищенным сексом с партнершей, которая страдает бактериальным вагинозом.
Сам по себе дисбактериоз не заразный. Однако попадание патогенной микрофлоры на головку полового члена может вызвать воспалительный процесс. Это происходит из-за высокой концентрации болезнетворных бактерий во влагалище женщины.
Таким образом у мужчин может развиваться баланопостит. Длительное воспаление головки полового члена, а иногда и крайней плоти, может вызывать атрофию тканей. Именно поэтому мужчине нужно срочно обращаться к врачу, если проявляются первые тревожные симптомы. Доктор назначает антибактериальную терапию, и в течение недели недуг полностью излечивается.
Единственной профилактикой подобного недуга у мужской части населения является использование барьерного метода контрацепции – презерватива.
Симптомы нарушений микрофлоры
Дисбиоз – не заболевание, а состояние, при котором нарушается нормальный баланс микрофлоры. Такое состояние может продолжаться в течение длительного времени, не вызывая патологических или характерных симптомов. В этом заключается основная опасность дисбиоза – он способствует развитию многих заболеваний, которые при отсутствии ранней диагностики часто переходят в хроническую форму.
Проявления нарушения экосистемы могут быть разными и зависят от типа микроорганизмов, которые начали активно развиваться.
Из общих симптомов, которые помогают заподозрить патологию, можно выделить:
- ухудшение общего самочувствия, у женщины появляется необъяснимая усталость, снижается иммунитет, возникают расстройства пищеварения и ослабляется половое влечение;
- местный дискомфорт в области гениталий – жжение или зуд;
- неприятные ощущения при половом контакте;
- изменения характера ежедневных влагалищных выделений – один из основных признаков дисбиоза.
Появление проблем в женской сфере действительно можно легко заподозрить по изменению ежедневного влагалищного секрета. Если слизь приобретает густоту и творожистую консистенцию, существует высокая вероятность развития кандидоза. Если же выделения начинают неприятно пахнуть рыбой и меняют цвет на желто-зеленый, это свидетельствует о бактериальном вагинозе. По характеру выделений врач может поставить предположительный диагноз, который затем подтверждает лабораторными исследованиями. Лечение назначается только после точного выявления возбудителя.
Особенности диагностики
Для выявления нарушений в балансе влагалищной микрофлоры женщине необходимо сдать мазок на флору. Его берет гинеколог во время осмотра на гинекологическом кресле. Если по результатам исследования будут выявлены какие-либо патологические изменения, пациентке будет назначено лечение, включающее в себя санацию влагалища, местное применение мазей и гелей, а также прием лакто- и бифидобактерий для восстановления кисломолочной среды.
В период обострения заболевания врач может определить бактериальный вагиноз даже во время осмотра женщины, так как симптоматика в этом случае будет довольно выраженной. Но даже в этом случае пациентке необходимо сдать анализ мочи и крови и мазок на бактериальный посев, так как для назначения правильного лечения необходимо выявить, какие именно бактерии преобладают во влагалищной среде. Некоторые препараты эффективно справляются с грамотрицательными микроорганизмами, при этом их применение в отношении грамположительных бактерий будет неэффективным, поэтому отказываться от прохождения исследования не нужно.
Что такое дисбактериоз влагалища
Чтобы результат теста был максимально достоверным, необходимо правильно подготовиться к анализу. Для этого нужно:
- в день посещения гинеколога подмыться без использования моющих средств (желательно не пользоваться ароматизированной туалетной бумагой и гигиеническими прокладками с добавлением ароматизаторов);
- накануне исследования прекратить прием антибактериальных средств (проконсультироваться с врачом, так как лечение некоторыми препаратами прерывать нельзя);
- за стуки до анализа не употреблять острую, копченую, жирную пищу;
- за 3-4 дня отказаться от частых подмываний (лучше в этот период использовать просто теплую воду без мыла) и спринцеваний.
Важно! При отсутствии лечения бактериальный вагиноз может стать причиной половых инфекций, воспалительных заболеваний мочеиспускательной системы и половых органов, поэтому важно знать признаки и симптомы патологии, чтобы своевременно принять необходимые меры.
Диагностика при дисбактериозе влагалища
Профилактика дисбиоза
Поддерживать нормальный уровень микрофлоры влагалища очень важно для предупреждения многих заболеваний. Некоторые рекомендации, которые помогут предупредить патологический сдвиг баланса:
- необходимо своевременно и до конца проводить лечение урогенитальных заболеваний. Недолеченная патология приводит к тому, что воспалительный процесс в органах остается и переходит в хроническую форму;
- стабилизация гормонального фона. Временные гормональные сбои возможны в период беременности, а постоянные проблемы наблюдаются при эндокринных заболеваниях. Ситуация корректируется заместительной терапией после комплексной диагностики;
- женщинам не стоит увлекаться спринцеванием. Несмотря на популярность подобной процедуры, она вымывает полезные бактерии и уменьшает защитные свойства слизистой влагалища.
Провоцирующие факторы возникновения вагиноза
Помимо основных причин дисбактериоза, важно определить провоцирующие факторы заболевания. К ним относят бактерии, вид которых помогут определить выявленные симптомы заболевания у женщин.Основные виды бактерий, провоцирующий вагиноз:
- Стрептококки и стафилококки;
- Гарднереллы;
- Микоплазмы и уреаплазмы;
- Возбудитель молочницы – грибок Кандида;
- Клостридии, клебсиеллы, коринебактерии;
- Кишечная палочка.
При наличии бактерий в небольшом количестве, они приносят вреда здоровью, но при размножении и распространении вызывают болезнь.